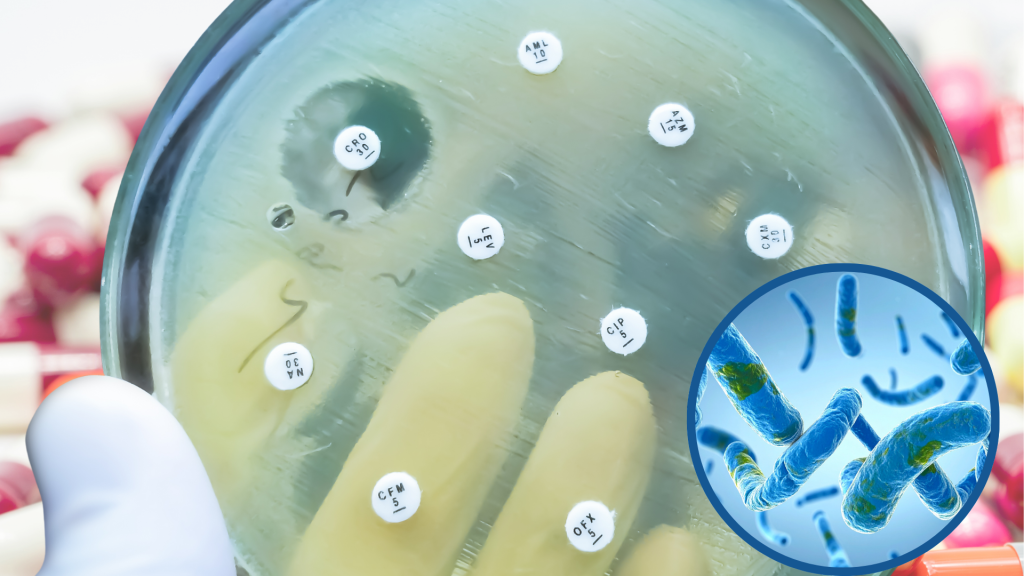
10 million people worldwide have active tb ~ the infectious form of tuberculosis (23)

Antibiotics were oncepowerful tools against infections, but their effectiveness has declined as antibiotic-resistant bacteria continue to rise and spread.
Multidrug-resistant organisms (MDROs) are now a major contributor to hospital-acquired infections. Their presence extends beyond hospitals. MDROs can also be found in our environment and surroundings.


The spread of AMR is a global, multifaceted issue shaped by human behaviour, animal health, food production, agriculture, and the environment.
Human antibiotic misuse

Overuse, misuse, and incomplete antibiotic treatment in humans prevent full elimination of bacteria and promote the survival of resistant strains.
Hospital transmission

Hospital settings enable AMR spread through direct contact and weak infection control.
Environmental spread

Wastewater from hospitals and households carries resistant bacteria and resistance genes into the environment, contributing to wider AMR dissemination.
Treating & Preventing Disease

Animals are given antibiotics to treat sickness, prevent disease, and sometimes to help them grow faster. Using low doses of antibiotics can let resistant bacteria survive and multiply.
Transmission to humans

These resistant bacteria can spread to humans through direct contact or by eating contaminated food.
Environmental spread via animal waste

Animal waste can also carry resistant bacteria into soil and water.
Environmental contamination

Wastewater from hospitals, homes, farms, and pharmaceutical plants introduces antibiotics and resistant bacteria into water and soil.
Treatment plant limitation

Treatment plants often cannot fully remove these substances, creating reservoirs of resistance.
Spread of resistance genes

Resistance genes in the environment can be adapted by other bacteria, spreading antimicrobial resistance.
Gene sharing across sectors

Bacteria in all sectors (human, animal, environment) can share resistance genes via horizontal gene transfer.
Accelerated resistance spread

These shared genes accelerate the spread of resistance across bacterial populations.

AMR spreads through humans, animals, and the environment. Resistant bacteria can survive on contaminated surfaces, in water, soil, and food, and move between people, animals, and communities. Poor hygiene, improper waste management, and overuse of antibiotics all accelerate their spread, making infections harder to control. Controlling AMR requires clean environments, responsible antibiotic use, public awareness to reduce transmission, and effective policies to prevent its spread.